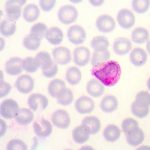

Malarone tablet
Malarone is suitable for most malaria areas. The treatment consists of a daily dose taken from two days before travel until one week after leaving the malaria area.
About the medication
- Dosage: The usual dose for malaria prevention for adults is 250 mg per day.
- How to take: Take one 250 mg tablet a day starting two days before you travel. Continue taking one tablet a day until 7 days after leaving the malaria area.
- Side effects: As most medications, Malarone can cause side effects in some patients. Possible side effects include headache and digestive problems.
- Who can take it: Malarone is a prescription only medication, so a healthcare professional needs to assess whether you can use it. It is not suitable for women who are pregnant or breastfeeding.
- Additional precautions: Take Malarone exactly as it’s been prescribed to you. In addition to taking your tablets you need to practise mosquito bite avoidance.
Prices
| Course | Depends on duration of travel |
| Pack size | Differs between brands |
| Price | £3.00 per tablet |
How it Works
Attend your consultation
Get your treatment
Frequently Asked Question
How to take Malarone for malaria prevention?
You need to take one 250mg tablet of Malarone starting two days before you leave for a malaria country.
Your course will continue for the duration of your trip and for 7 days after your return.
Take the daily dose with a meal or a milky drink. You should take it at the same time every day.
It is very important that you complete the course after your return. The malaria parasite can survive in your body for some time and stopping your treatment early could put you at risk of developing malaria even if you have already left the risk area.
If you are sick within an hour of taking Malarone, you need to take another tablet straight away as there may not have been enough time for the medication to work. You still need to finish your course as prescribed, so you will need to get a prescription for any additional tablets you may need to complete your course.
If you forget to take a dose take it as soon as you remember, then continue your course at the correct time. Don’t take a double dose to make up for the tablet you missed.
While Malarone is highly effective in preventing malaria, you also need to take precautions to avoid insect bites.
It is very unlikely that you catch malaria if you practise insect bite avoidance and take your tablets as prescribed. However, if you experience malaria symptoms during or after your trip it is important that you see a doctor without delay.
Who can take it?
As with all prescription medications, it is important that a healthcare professional assesses whether Malarone is suitable for you.
During your travel health appointment, the nurse or pharmacist will ask you questions about your travel itinerary and your general health as well as any medications you are taking. They will use this information to assess which antimalarial is best for you. They will also ask you about your preference.
Malarone won’t be suitable for you if you are allergic to any of the ingredients. It may also not be suitable if you suffer from certain medical problems, for example kidney disease. The prescribing nurse of pharmacist will also check which other medications you are currently taking and they will assess whether they interact with Malarone.
Malarone is not suitable for women who are pregnant or breastfeeding.
Side effects
Malarone is usually well tolerated. However, as most medications it can cause side effects in some patients.
Very common side effects include:
- headache
- nausea and vomiting
- stomach pain
- diarrhoea
Common side effects include:
- dizziness
- insomnia
- strange dreams
- depression
- loss of appetite
- fever
- rash which may be itchy
- cough
Malarone may also affect your blood test results.
For a full list of all side effects, please read the patient leaflet supplied with your medication.
See a doctor without delay if you experience the following side effects:
- Rash and itching
- Difficulty breathing and wheezing
- Swellings of the face or throat
These symptoms could be a sign that you are suffering from an allergic reaction that requires urgent attention.